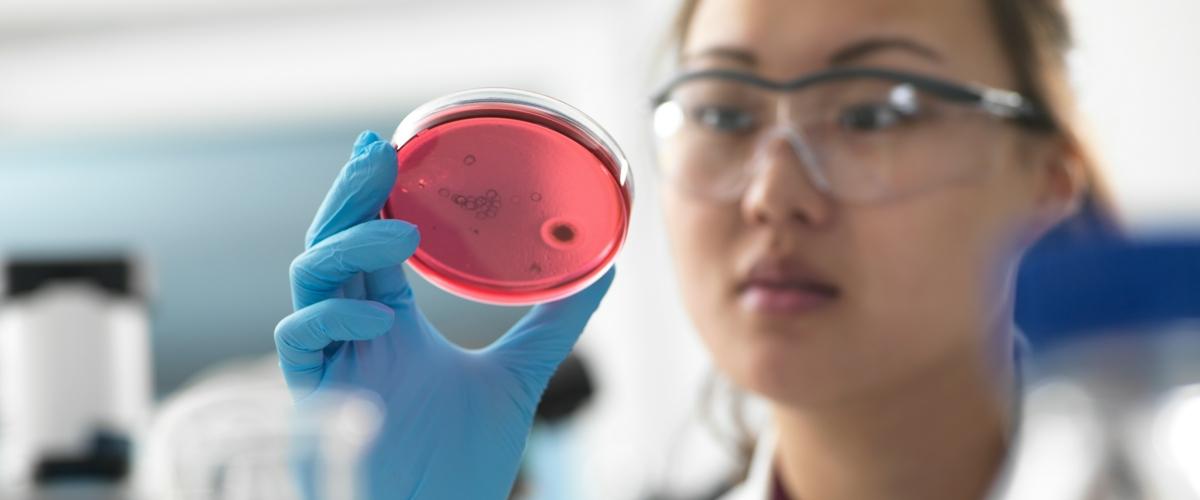
TODO:

С возрастом кровеносные сосуды становятся более уязвимыми к повреждениям, что повышает риск сердечно-сосудистых заболеваний. Причины этого не до конца ясны. По мнению ученых Колорадского университета в Боулдере, в старении наших сосудов следует винить симбиотические бактерии.
Как сообщает Science Daily, ученые провели ряд экспериментов с лабораторными мышами разного возраста. Кишечную микрофлору грызунов уничтожили антибиотиками широкого спектра действия, а спустя 3-4 недели оценили состояние их сосудов и измерили биомаркеры старения.
Анализ не выявил никаких изменений в состоянии сосудов молодых мышей. Однако у их старых сородичей были отмечены заметные улучшения, в том числе по биохимическим показателям.
Например, в их крови снизилась концентрация воспалительных соединений и свободных радикалов.
Исследователи предположили, что причиной возрастного повреждения сосудов могли быть какие-то бактерии, населяющие кишечник. Чтобы выявить их, пришлось отсеквенировать образцы фекалий молодых и старых особей — не из группы, обработанной антибиотиками.
Анализ показал, что у старых мышей повышена концентрация микроорганизмов, связанных с воспалительными процессами, например, Desulfovibrio. Кроме того, в их микробиоме было больше протеобактерий — к этой группе относятся возбудители сальмонеллеза и некоторых других заболеваний.
Возможно, бактерии влияли на здоровье сосудов за счет выделения определенных химических соединений, например, триметиламиноксида, который ассоциирован с повышенным риском инфаркта и инсульта. В крови стареющих мышей этого метаболита было в три раза больше, чем у молодых.
Авторы работы подчеркивают, что уничтожение кишечной микрофлоры — всего лишь экспериментальный инструмент. Его ни в коем случае нельзя считать способом борьбы со старением, поскольку у антибиотиков слишком много побочных эффектов. Вместо этого ученые предлагают изменить диету, включив в нее больше продуктов, благоприятных для здорового микробиома.
Некоторые бактерии, населяющие наш организм, могут быть еще более опасными. Например, оральная бактерия Fusobacterium nucleatum повышает риск рака толстой кишки, а ее «соседка» Porphyromonas gingivalis может быть одной из причин болезни Альцгеймера. А знаменитая Helicobacter pylori способна вызывать не только гастрит и язву, но и рак.